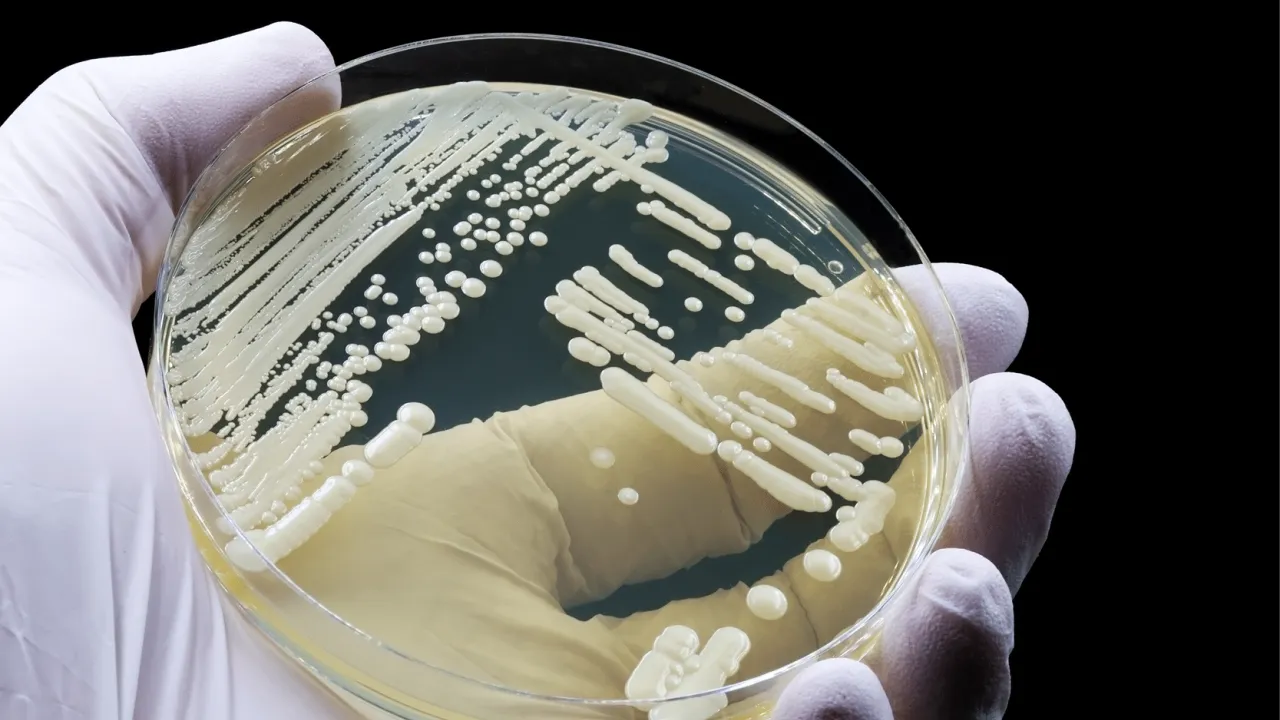

Candida auris: Dirençli mantar dünya genelinde yeni sağlık tehdidi
Sağlık otoriteleri, son yıllarda bildirimi artan Candida auris enfeksiyonlarına karşı uyarılarını yükseltiyor. Çoklu ilaç direnci, hızlı yayılım ve hastane ortamında kalıcılığı nedeniyle bu mantar, bulaşıcı hastalıklar alanında yeni bir küresel risk olarak değerlendiriliyor.
Candida auris, ilk kez 2009 yılında tanımlandı ancak kısa sürede birçok ülkeye yayıldı. Özellikle yoğun bakım üniteleri, uzun süre hastanede yatanlar ve bağışıklık sistemi zayıf hastalarda ciddi enfeksiyonlara yol açabiliyor. En önemli sorunlardan biri, mantarın bazı antifungal ilaçlara direnç geliştirmiş olması.
Neden tehlikeli kabul ediliyor?
Uzmanlara göre Candida auris’i farklı ve tehlikeli kılan özellikler şöyle:
• birçok antifungal ilaca direnç geliştirebilmesi
• yüzeylerde uzun süre yaşayabilmesi
• hastane odası, yatak korkuluğu ve tıbbi ekipmanlarda tutunabilmesi
• standart laboratuvar yöntemleriyle başka türlerle karıştırılabilmesi
Bu özellikler, enfeksiyon kontrolünü güçleştiriyor ve salgınlara zemin hazırlıyor.
Belirtiler neler?
Hastalık çoğu zaman belirti vermeden deride kolonizasyon yapabiliyor. Enfeksiyon geliştiğinde ise:
• yüksek ateş
• titreme
• halsizlik
• mevcut enfeksiyon tedavisine rağmen klinik düzelmeme
gibi şikayetler görülebiliyor. Özellikle kan dolaşımı enfeksiyonları ağır seyredebildiği için erken tanı büyük önem taşıyor.
Kimler daha risk altında?
Risk grupları şu şekilde özetleniyor:
• yoğun bakım hastaları
• damar içi kateter kullananlar
• uzun süre antibiyotik veya antifungal alanlar
• kronik hastalığı olanlar
• bağışıklık sistemi baskılanmış bireyler
Bu nedenle enfeksiyon kontrol önlemleri, hastane hijyeni ve izolasyon uygulamaları hayati görülüyor.
Bilimsel çalışmalar ne söylüyor?
Son yıllarda saygın tıp dergilerinde Candida auris üzerine çok sayıda çalışma yayımlandı. Bu yayınlarda özellikle şu noktalar vurgulanıyor:
• çoklu ilaç direncinin genetik mekanizmaları
• biyofilm oluşturma kapasitesi
• çevre yüzeylerinde kalıcılığı
• yeni antifungal ilaç adayları
• hızlı tanı testlerinin geliştirilmesi
Çalışmalar, erken taramanın ve temas izolasyonunun salgınları önlemede kilit rol oynadığını gösteriyor. Ayrıca yeni nesil antifungal ilaçlar ve kombinasyon tedavileri üzerine klinik araştırmalar devam ediyor.
Ne yapılmalı?
Uzmanlar, panik yerine bilinçli önlem çağrısı yapıyor. Öneriler şöyle özetleniyor:
• hastane enfeksiyon kontrolüne titizlikle uyulması
• riskli hastalarda tarama yapılması
• yüzey dezenfeksiyonunun artırılması
• gereksiz antibiyotik kullanımının azaltılması
• halkın doğru bilgilendirilmesi
Candida auris, sessiz ama ciddiye alınması gereken bir ziyaretçi gibi sağlık sistemlerinin kapısını zorluyor. Erken tanı, güçlü laboratuvar altyapısı ve akılcı ilaç kullanımı, bu görünmez tehdide karşı en güçlü kalkan olarak gösteriliyor.